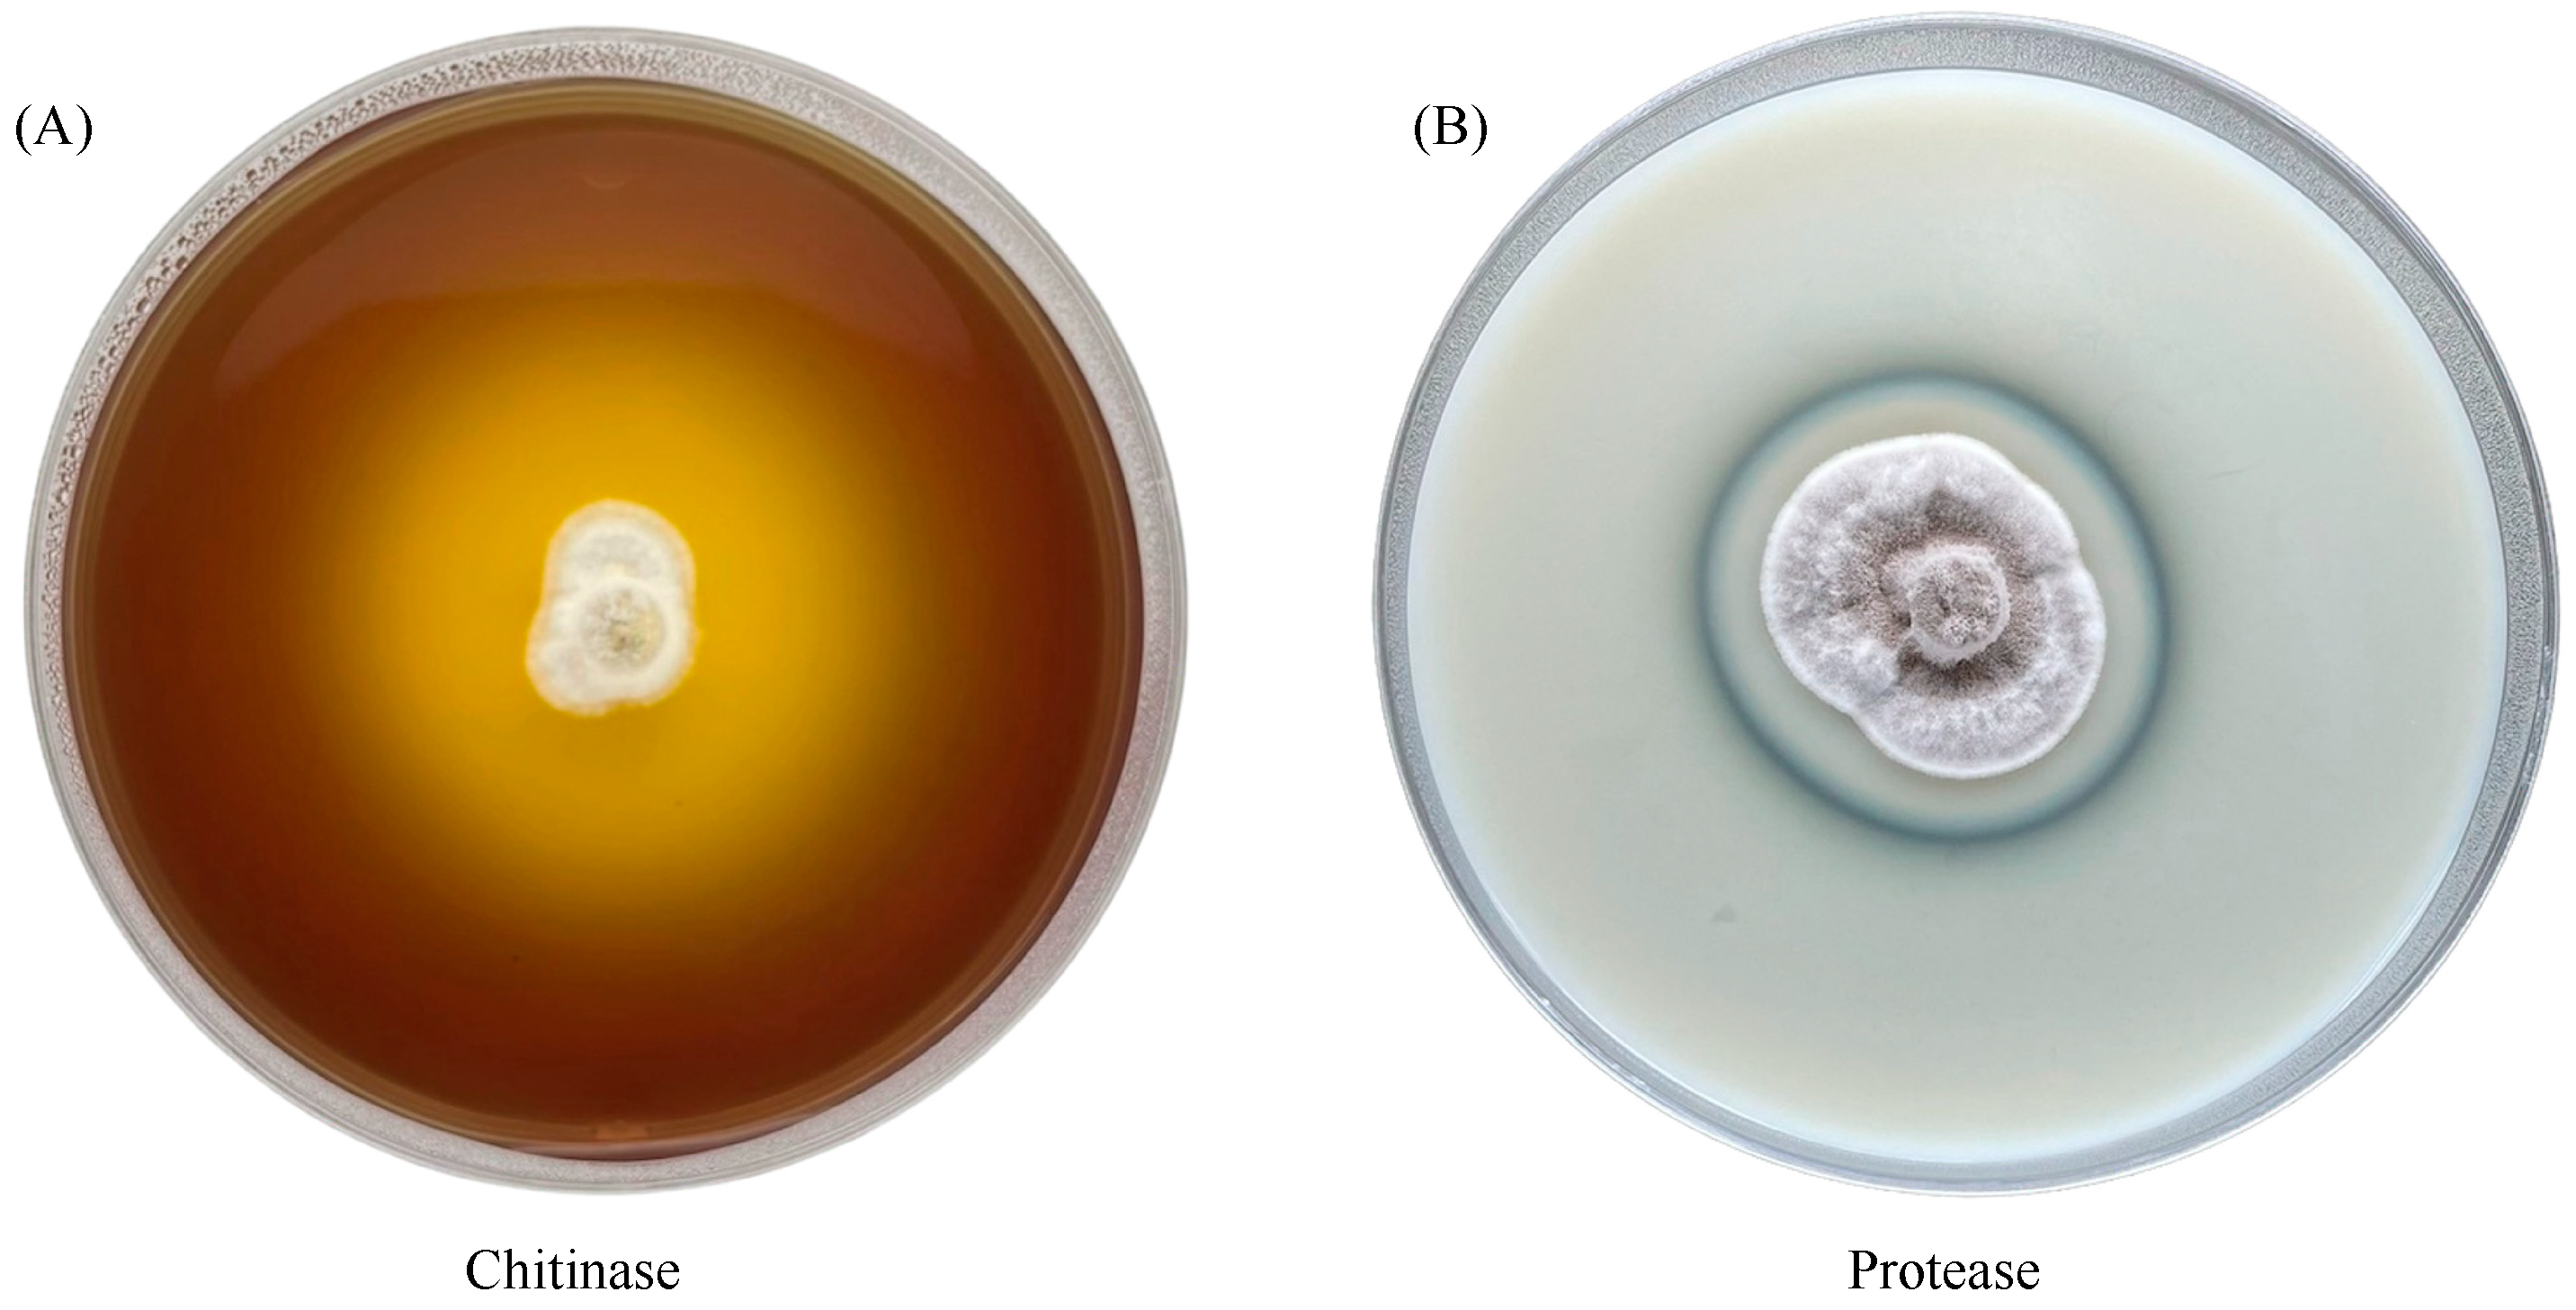
Insects 15 00565 g007 Insects 15 00565 g007

Histopathological Alterations in Nilaparvata lugens (Hemiptera: Delphacidae) after Exposure to Cordyceps javanica
Abstract
Simple Summary
Abstract
1. Introduction
2. Materials and Methods
2.1. DNA Extraction and Phylogenetic Analysis of Cordyceps javanica
2.2. Nilaparvata Lugens Preparation
2.3. Cordyceps javanica Preparation
2.4. Infection and Morpho-Histological Examination
2.5. Production and Measurement of Cuticle Degrading Enzymes
2.5.1. Chitinase Activity
2.5.2. Protease Activity
2.6. Data Analysis and Statistical Analysis
3. Results
3.1. Phylogenetic Analysis
3.2. The Mortality Rate of BPH-Infected Cordyceps javanica
3.3. Morphology and Histopathology of Nilaparvata lugens (BPH)
3.4. Activity of Cuticle- and Protein-Degrading Enzymes
4. Discussion
5. Conclusions
Author Contributions
Funding
Data Availability Statement
Acknowledgments
Conflicts of Interest
References
- Xue, J.; Bao, Y.Y.; Li, B.L.; Cheng, Y.B.; Peng, Z.Y. Transcriptome analysis of the brown planthopper Nilaparvata lugens. PLoS ONE 2010, 5, e14233. [Google Scholar] [CrossRef] [PubMed]
- Kumar, S.; Singh, H.; Patel, A.; Patel, J.N.; Kant, C. Brown plant hopper, Nilaparvata lugens (Stal) (Insecta: Delphacidae) a major insect of rice in India: A review. J. Entomol. Res. 2022, 46, 333–338. [Google Scholar] [CrossRef]
- Matsumura, M.; Sanada-Morimura, S.; Otuka, A.; Sonoda, S.; Van Thanh, D.; Van Chien, H.; Huang, S.H. Insecticide susceptibilities of the two rice planthoppers Nilaparvata lugens and Sogatella furcifera in East Asia, the Red River Delta, and the Mekong Delta. Pest Manag. Sci. 2018, 74, 456–464. [Google Scholar] [CrossRef] [PubMed]
- Bottrell, D.G.; Schoenly, K.G. Resurrecting the ghost of green revolutions past: The brown planthopper as a recurring threat to high-yielding rice production in tropical Asia. J. Asia-Pac. Entomol. 2012, 15, 122–140. [Google Scholar] [CrossRef]
- Tang, B.; Xu, K.; Liu, Y.; Zhou, Z.; Karthi, S.; Yang, H.; Li, C. A review of physiological resistance to insecticide stress in Nilaparvata lugens. 3 Biotech 2022, 12, 84. [Google Scholar] [CrossRef] [PubMed]
- Mu, X.C.; Zhang, W.; Wang, L.X.; Zhang, S.; Zhang, K.; Gao, C.F.; Pati, P.; Jena, M.; Bhattacharya, S.; Behera, S.K.; et al. Biochemical defense responses in red rice genotypes possessing differential resistance to brown planthopper, Nilaparvata lugens (Stål). Insects 2023, 14, 632. [Google Scholar] [CrossRef] [PubMed]
- Thomas, M.B. Ecological approaches and the development of “truly integrated” pest management. Proc. Natl. Acad. Sci. USA 1999, 96, 5944–5951. [Google Scholar] [CrossRef]
- Zhao, Q.; Ye, L.; Wang, Z. Sustainable control of the rice pest, Nilaparvata lugens, using the entomopathogenic fungus Isaria javanica. Pest Manag. Sci. 2021, 77, 1452–1464. [Google Scholar] [CrossRef] [PubMed]
- Humber, R.A. Identification of Entomopathogenic Fungi Manual of Techniques in Invertebrate Pathology, 2nd ed.; Academic Press: Cambridge, MA, USA, 2012. [Google Scholar]
- Bugti, G.A.; Na, C.; Bin, W.; Lin, H.F. Control of plant sap-sucking insects using entomopathogenic fungi Isaria fumosorosea strain (Ifu13a). Plant Prot. Sci. 2018, 54, 258–264. [Google Scholar] [CrossRef]
- Jaber, R.L.; Ownley, B.H. Can we use entomopathogenic fungi as endophytes for dual biological control of insect pests and plant pathogens. Biol. Control 2017, 107, 50–59. [Google Scholar] [CrossRef]
- Vilcinskas, A. Coevolution between pathogen-derived proteinases and proteinase inhibitors of host insects. Virulence 2010, 1, 206–214. [Google Scholar] [CrossRef]
- Ortiz-Urquiza, A.; Keyhani, N.O. Action on the surface: Entomopathogenic fungi versus the insect cuticle. Insects 2013, 4, 357–374. [Google Scholar] [CrossRef]
- Joop, G.; Vilcinskas, A. Coevolution of parasitic fungi and insect hosts. Zoology 2016, 119, 350–358. [Google Scholar] [CrossRef]
- Rafanomezantsoa-Randriambololona, B.; Avé, P.; Papierok, B. Histology of insect infection by entomopathogenic fungi: Interest in a new procedure for the study of precocious phases. Bull. Soc. Pathol. Exot. 1992, 85, 69–75. [Google Scholar]
- Lee, K.; Lockhart, J.H.; Xie, M.; Chaudhary, R.; Slebos, R.J.; Flores, E.R.; Chung, C.H.; Tan, A.C. Deep learning of histopathology images at the single cell level. Front. Artif. Intell. 2021, 4, 754641. [Google Scholar] [CrossRef]
- Lussier, J.; Racine, E.; Benoit-Biancamano, M.O. Histology of the whole body of honey bees: Tissue fixation and processing. J. Vet. Diagn. Investig. 2023, 35, 625–629. [Google Scholar] [CrossRef]
- Sabino, R.; Wiederhold, N. Diagnosis from Tissue: Histology and Identification. J. Fungi. 2022, 8, 505. [Google Scholar] [CrossRef]
- Chen, X.; Sun, L.; Zhang, Y.X.; Zhao, L.L.; Lin, J.Z. Differing infection of Isaria fumosorosea (Wize) Brown & Smith in an aphid (Myzus persicae [Sulzer]) and predatory mite (Neoseiulus cucumeris [Oudemans]) under a scanning electron microscope. Syst. Appl. Acarol. 2020, 25, 2263–2272. [Google Scholar]
- Tian, J.; Diao, H.; Liang, L.; Hao, C.; Arthurs, S.; Ma, R. Pathogenicity of Isaria fumosorosea to Bemisia tabaci, with some observations on the fungal infection process and host immune response. J. Invertebr. Pathol. 2015, 130, 147–153. [Google Scholar] [CrossRef]
- Saitoh, K.; Togashi, K.; Arie, T.; Teraoka, T. A simple method for a mini-preparation of fungal DNA. J. Gen. Plant Pathol. 2006, 72, 348–350. [Google Scholar] [CrossRef]
- White, T.J.; Bruns, T.; Lee, S.H.; Taylor, J.W. PCR Protocols: A Guide to Methods and Application; Academic Press: London, UK, 1990; pp. 315–322. [Google Scholar]
- Glass, N.L.; Donaldson, G.C. Development of primer sets designed for use with the PCR to amplify conserved genes from filamentous ascomycetes. Appl. Environ. Microbiol. 1995, 61, 1323–1330. [Google Scholar] [CrossRef]
- Ou, D.; Zhang, L.H.; Guo, C.; Chen, X.S.; Ali, S.; Qiu, B.L. Identification of a new Cordyceps javanica fungus isolate and its toxicity evaluation against Asian citrus psyllid. MicrobiologyOpen 2018, 8, e760. [Google Scholar] [CrossRef]
- Hall, T.A. BioEdit: A user-friendly biological sequence alignment editor and analysis program for Windows 95/98/NT. Nucl. Acids. Symp. Ser. 1999, 41, 95–98. [Google Scholar]
- Kumar, S.; Stecher, G.; Li, M.; Knyaz, C.; Tamura, K. MEGA X: Molecular evolutionary genetics analysis across computing platforms. Mol. Biol. Evol. 2018, 35, 1547–1549. [Google Scholar] [CrossRef]
- Ronquist, F.; Teslenko, M.; van der Mark, P.; Ayres, D.L.; Darling, A.; Höhna, S.; Larget, B.; Liu, L.; Suchard, M.A.; Huelsenbeck, J.P. MRBAYES 3.2: Efficient bayesian phylogenetic inference and model selection across a large model space. Syst. Biol. 2012, 61, 539–542. [Google Scholar] [CrossRef]
- Kongthong, K.; Charoenphon, N.; Thaochan, N.; Boonyoung, P.; Lida, A.; Jeamah, A.; Imsonpang, S.; Wongkamhaeng, K.; Kongtueng, P.; Senarat, S. A histological method for marine invertebrates. Vet. Integr. Sci. 2023, 21, 251–263. [Google Scholar] [CrossRef]
- Wang, S.; Lai, J.; Wu, R.; Zhang, L.; Huang, M.; Xiao, Y.; Zhang, X.; Chen, J. Grocott methenamine silver staining is the optimal approach to histological diagnosis of pulmonary cryptococcosis. Front. Microbiol. 2022, 13, 885511. [Google Scholar] [CrossRef]
- Abbott, W.S. A method of computing the effectiveness of an insecticide. J. Econ. Entomol. 1925, 18, 265–267. [Google Scholar] [CrossRef]
- Singh, R.; Yadav, S.K.; Kapoor, N. Analysis of application of digital image analysis in histopathology quality control. J. Pathol. Inform. 2023, 14, 100322. [Google Scholar] [CrossRef]
- Thaochan, N.; Chandrapatya, A. The phenotypic and metabolic properties of Metarhizium guizhouense on Corcyra cephalonica. Mycosphere 2016, 7, 214–225. [Google Scholar] [CrossRef]
- Bradner, J.; Gillings, M.; Nevalainen, K. Qualitative assessment of hydrolytic activities in Antarctic microfungi grown at different temperatures on solid media. World J. Microbiol. Biotechnol. 1999, 15, 131–132. [Google Scholar] [CrossRef]
- Deka, B.; Baruah, C.; Babu, A. Entomopathogenic microorganisms: Their role in insect pest management. Egypt. J. Biol. Pest Control 2021, 31, 1–8. [Google Scholar] [CrossRef]
- Farooq, M.; Freed, S. Infectivity of housefly, Musca domestica (Diptera: Muscidae) to different entomopathogenic fungi. Braz. J. Microbiol. 2016, 47, 807–816. [Google Scholar] [CrossRef][Green Version]
- Domingues, M.M.; Santos, P.L.; Gêa, B.C.C.; Carvalho, V.R.; Oliveira, F.N.; Soliman, E.P.; Silva, W.M.; Zanuncio, J.C.; Santos Junior, V.C.; Wilcken, C.F. Isolation and molecular characterization of Cordyceps sp. from Bemisia tabaci (Hemiptera: Aleyrodidae) and pathogenic to Glycaspis brimblecombei (Hemiptera: Aphalaridae). Braz. J. Biol. 2022, 84, e253028. [Google Scholar] [CrossRef]
- Behle, R.W.; Wu, S.; Toews, M.D.; Duffield, K.R.; Shapiro-Ilan, D.I. Comparing production and efficacy of Cordyceps javanica with Cordyceps fumosorosea. J. Econ. Entomol. 2022, 115, 455–461. [Google Scholar] [CrossRef]
- Wang, D.; Xing, P.X.; Diao, H.L.; Zhou, W.W.; Li, X.W.; Zhang, L.J.; Ma, R.Y. Pathogenicity characteristics of the entomopathogenic fungus Cordyceps javanica IJ-tg19 to Acyrthosiphon pisum. BioControl 2023, 68, 447–458. [Google Scholar] [CrossRef]
- Cabanillas, H.E.; de León, J.H.; Humber, R.A.; Murray, K.D.; Jones, W.A. Isaria poprawskii sp. nov. (Hypocreales: Cordycipitaceae), a new entomopathogenic fungus from Texas affecting sweet potato whitefly. Mycoscience 2013, 54, 158–169. [Google Scholar] [CrossRef]
- Gallou, A.; Serna-Domínguez, M.G.; Berlanga-Padilla, A.M.; AyalaZermeño, M.A.; Mellín-Rosas, M.A.; Montesinos-Matías, R.; Arredondo-Bernal, H.C. Species clarification of Isaria isolates used as biocontrol agents against Diaphorina citri (Hemiptera: Liviidae) in Mexico. Fungal Biol. 2016, 120, 414–423. [Google Scholar] [CrossRef]
- Wang, L.; Qu, L.; Hu, J.; Zhang, L.; Tang, F.; Lu, M. Metabolomics reveals constitutive metabolites that contribute resistance to fall webworm (Hyphantria cunea) in Populus deltoides. Environ. Exp. Bot. 2017, 136, 31–40. [Google Scholar] [CrossRef]
- Liu, Y.; Yang, Y.; Wang, B. Entomopathogenic fungi Beauveria bassiana and Metarhizium anisopliae play roles of maize (Zea mays) growth promoter. Sci. Rep. 2022, 12, 15706. [Google Scholar] [CrossRef]
- Bidochka, M.J.; Khachatourians, G.G. Protein hydrolysis in grasshopper cuticles by entomopathogenic fungal extracellular proteases. J. Invertebr. Pathol. 1994, 63, 7–13. [Google Scholar] [CrossRef]

| Enzymes | Diameter (mm) of Degradation Zone (R) (Diameter of Clear Zone + Diameter of Colony) | Diameter (mm) of Colony (r) | Enzyme Index (EI) = Diameter of Degradation Zone (R)/Diameter of Colony (r) | ||||||
|---|---|---|---|---|---|---|---|---|---|
| 5 Days | 7 Days | 9 Days | 5 Days | 7 Days | 9 Days | 5 Days | 7 Days | 9 Days | |
| Chitinase | 35.00 ± 0.00 b | 53.33 ± 1.67 c | 24.17 ± 0.44 a | 12.67 ± 0.33 a | 20.00 ± 0.29 b | 24.17 ± 0.44 c | 2.77 ± 0.07 b | 2.67 ± 0.12 b | 1.00 ± 0.00 a |
| Protease | 19.50 ± 0.29 a | 30.83 ± 0.60 b | 42.00 ± 0.76 c | 17.67 ± 0.33 a | 28.67 ± 0.44 b | 36.83 ± 0.17 c | 1.10 ± 0.01 ab | 1.08 ± 0.01 a | 1.14 ± 0.02 b |
Disclaimer/Publisher’s Note: The statements, opinions and data contained in all publications are solely those of the individual author(s) and contributor(s) and not of MDPI and/or the editor(s). MDPI and/or the editor(s) disclaim responsibility for any injury to people or property resulting from any ideas, methods, instructions or products referred to in the content. |
© 2024 by the authors. Licensee MDPI, Basel, Switzerland. This article is an open access article distributed under the terms and conditions of the Creative Commons Attribution (CC BY) license (https://creativecommons.org/licenses/by/4.0/).
Share and Cite
Bunsap, P.; Senarat, S.; Niyomdecha, S.; Pornsuriya, C.; Kaneko, G.; Thaochan, N. Histopathological Alterations in Nilaparvata lugens (Hemiptera: Delphacidae) after Exposure to Cordyceps javanica. Insects 2024, 15, 565. https://doi.org/10.3390/insects15080565
Bunsap P, Senarat S, Niyomdecha S, Pornsuriya C, Kaneko G, Thaochan N. Histopathological Alterations in Nilaparvata lugens (Hemiptera: Delphacidae) after Exposure to Cordyceps javanica. Insects. 2024; 15(8):565. https://doi.org/10.3390/insects15080565
Chicago/Turabian StyleBunsap, Peerasak, Sinlapachai Senarat, Seree Niyomdecha, Chaninun Pornsuriya, Gen Kaneko, and Narit Thaochan. 2024. "Histopathological Alterations in Nilaparvata lugens (Hemiptera: Delphacidae) after Exposure to Cordyceps javanica" Insects 15, no. 8: 565. https://doi.org/10.3390/insects15080565
APA StyleBunsap, P., Senarat, S., Niyomdecha, S., Pornsuriya, C., Kaneko, G., & Thaochan, N. (2024). Histopathological Alterations in Nilaparvata lugens (Hemiptera: Delphacidae) after Exposure to Cordyceps javanica. Insects, 15(8), 565. https://doi.org/10.3390/insects15080565

